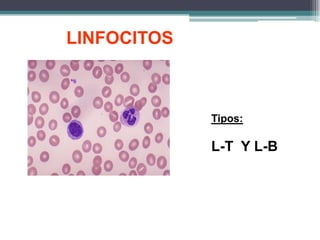
LINFOCITOS
Tipos:
L-T Y L-B

El documento clasifica y describe los diferentes tipos de tejido conectivo. Incluye tejido conectivo laxo, denso, adiposo, reticular y mucoso. Explica sus funciones principales como sostén, almacenamiento, reparación y transporte. Describe los componentes celulares como fibroblastos, células adiposas y linfocitos, así como los componentes de la matriz extracelular como fibras de colágeno y elastina.